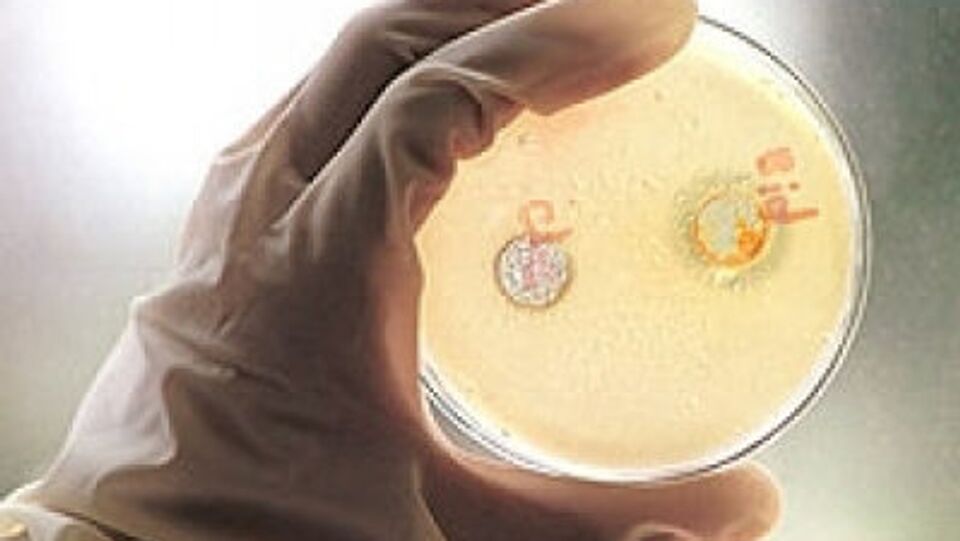
Вирусный гепатит

Пресс-конференция на тему: "Борьба с гепатитом в Молдове: причины заболевания и программы лечения". 28 июля отмечается Всемирный день борьбы с гепатитом. О причинах и статистике заболеваний, а также о программах лечения гепатита в Молдове рассказали эксперты.
Участники:
— директор Республиканской клинической инфекционной больницы имени Тома Чорбэ Виктор ДИАТИШИН;
— заведующая реанимационным отделением Республиканской клинической инфекционной больницы имени Тома Чорбэ Галина КИРЬЯКОВА.
Участники:
— директор Республиканской клинической инфекционной больницы имени Тома Чорбэ Виктор ДИАТИШИН;
— заведующая реанимационным отделением Республиканской клинической инфекционной больницы имени Тома Чорбэ Галина КИРЬЯКОВА.